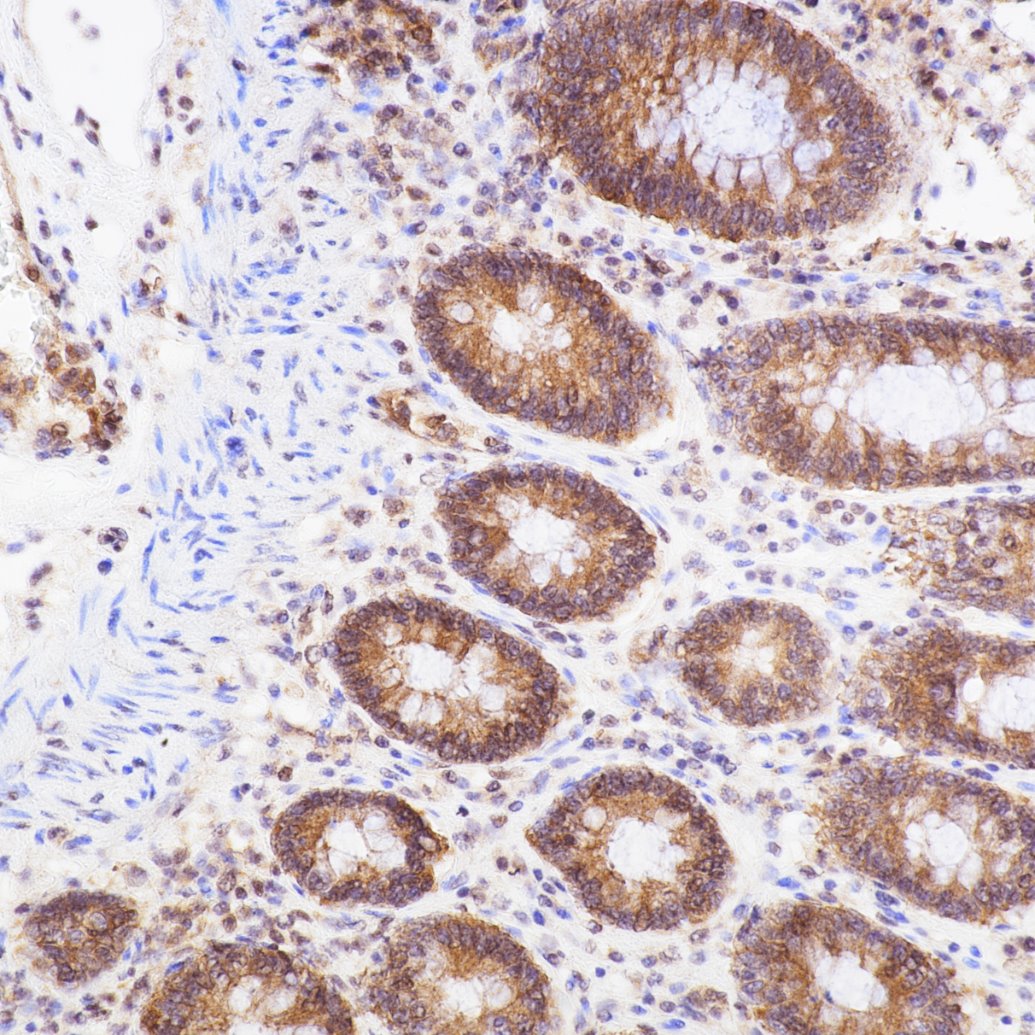
Immunohistochemistry (IHC) staining of human colon tissue using NF-κB p65 Recombinant monoclonal antibody (80979-1-RR)

Tested Applications
| Positive WB detected in | HeLa cells, HEK-293 cells, MCF-7 cells, MOLT-4 cells, Jurkat cells, Raji cells, NIH/3T3 cells, HSC-T6 cells |
| Positive IP detected in | HeLa cells |
| Positive IHC-Autostainer detected in | human colon tissue |
| Positive IF/ICC detected in | HepG2 cells, TNF alpha treated HT-1080 cells |
| Positive FC (Intra) detected in | HepG2 cells |
| Positive ChIP-qPCR detected in | hTNF (30 ng/ml, 1 h) HeLa cells |
Recommended dilution
| Application | Dilution |
|---|---|
| Western Blot (WB) | WB : 1:5000-1:40000 |
| Immunoprecipitation (IP) | IP : 0.5-4.0 ug for 1.0-3.0 mg of total protein lysate |
| Immunohistochemistry (IHC)-AUTOSTAINER | IHC-AUTOSTAINER : 1:500-1:2000 |
| Immunofluorescence (IF)/ICC | IF/ICC : 1:125-1:500 |
| Flow Cytometry (FC) (INTRA) | FC (INTRA) : 0.40 ug per 10^6 cells in a 100 µl suspension |
| CHIP-QPCR | CHIP-QPCR : 1:10-1:100 |
| It is recommended that this reagent should be titrated in each testing system to obtain optimal results. | |
| Sample-dependent, Check data in validation data gallery. | |
Published Applications
| WB | See 133 publications below |
| IHC | See 1 publications below |
| IF | See 29 publications below |
Product Information
80979-1-RR targets NF-κB p65 in WB, IHC-Autostainer, IF/ICC, FC (Intra), IP, ELISA, ChIP-qPCR applications and shows reactivity with human, mouse, rat samples.
| Tested Reactivity | human, mouse, rat |
| Cited Reactivity | human, mouse, rat, pig, chicken |
| Host / Isotype | Rabbit / IgG |
| Class | Recombinant |
| Type | Antibody |
| Immunogen |
CatNo: Ag1199 Product name: Recombinant human p65; RELA protein Source: e coli.-derived, PGEX-4T Tag: GST Domain: 1-220 aa of BC011603 Sequence: MDELFPLIFPAEPAQASGPYVEIIEQPKQRGMRFRYKCEGRSAGSIPGERSTDTTKTHPTIKINGYTGPGTVRISLVTKDPPHRPHPHELVGKDCRDGFYEAELCPDRCIHSFQNLGIQCVKKRDLEQAISQRIQTNNNPFQVPIEEQRGDYDLNAVRLCFQVTVRDPSGRPLRLPPVLSHPIFDNRAPNTAELKICRVNRNSGSCLGGDEIFLLCDKVQ Predict reactive species |
| Full Name | v-rel reticuloendotheliosis viral oncogene homolog A (avian) |
| Calculated Molecular Weight | 65 kDa |
| Observed Molecular Weight | 65 kDa |
| GenBank Accession Number | BC011603 |
| Gene Symbol | NF-κB p65 |
| Gene ID (NCBI) | 5970 |
| RRID | AB_2918923 |
| Conjugate | Unconjugated |
| Form | Liquid |
| Purification Method | Protein A purification |
| UNIPROT ID | Q04206 |
| Storage Buffer | PBS with 0.02% sodium azide and 50% glycerol, pH 7.3. |
| Storage Conditions | Store at -20°C. Stable for one year after shipment. Aliquoting is unnecessary for -20oC storage. 20ul sizes contain 0.1% BSA. |
Background Information
Nuclear factor kB (NF-kB) is a sequence-specific DNA-binding protein complex which regulates the expression of viral genomes, including the human immunodeficiency virus, and a variety of cellular genes, particularly those involved in immune and inflammatory responses. The members of the NF-kB family in mammalian cells include the proto-oncogene c-Rel,p50/p105 (NFkB1), p65 (RelA), p52/p100 (NFkB2), and RelB. All of these proteins share a conserved 300-amino acid region known as the Rel homology domain which is responsible for DNA binding, dimerization, and nuclear translocation of NF-kB. The p65 subunit is a major component of NF-kB complexes and is responsible for trans-activation. NF-kB heterodimeric p65-p50 and p65-c-Rel complexes are transcriptional activators. The NF-kB p65-p65 complex appears to be involved in invasin-mediated activation of IL-8 expression. The inhibitory effect of IkB upon NF-kB the cytoplasm is exerted primarily through the interaction with p65. p65 shows a weak DNA-binding site which could contribute directly to DNA binding in the NF-kB complex. It associates with chromatin at the NF-kB promoter region via association with DDX1. This antibody is a rabbit monoclonal antibody raised against residues near the N terminus of human RELA.
Protocols
| Product Specific Protocols | |
|---|---|
| FC protocol for NF-κB p65 antibody 80979-1-RR | Download protocol |
| IF protocol for NF-κB p65 antibody 80979-1-RR | Download protocol |
| IP protocol for NF-κB p65 antibody 80979-1-RR | Download protocol |
| WB protocol for NF-κB p65 antibody 80979-1-RR | Download protocol |
| Standard Protocols | |
|---|---|
| Click here to view our Standard Protocols |
Publications
| Species | Application | Title |
|---|---|---|
Adv Sci (Weinh) Ccl2-Induced Regulatory T Cells Balance Inflammation Through Macrophage Polarization During Liver Reconstitution | ||
J Nanobiotechnology Efficacy and safety of Fe-curcumin coordination polymer nanodots to prevent corneal neovascularization in alkali burn models | ||
Redox Biol Deficiency of S100 calcium binding protein A9 attenuates vascular dysfunction in aged mice | ||
J Exp Clin Cancer Res METTL3 recruiting M2-type immunosuppressed macrophages by targeting m6A-SNAIL-CXCL2 axis to promote colorectal cancer pulmonary metastasis | ||
Carbohydr Polym Structural characterizations and antiaging activities of hydrolyzed low-molecular-weight polysaccharides from Polygoni Multiflori Radix Praeparata |